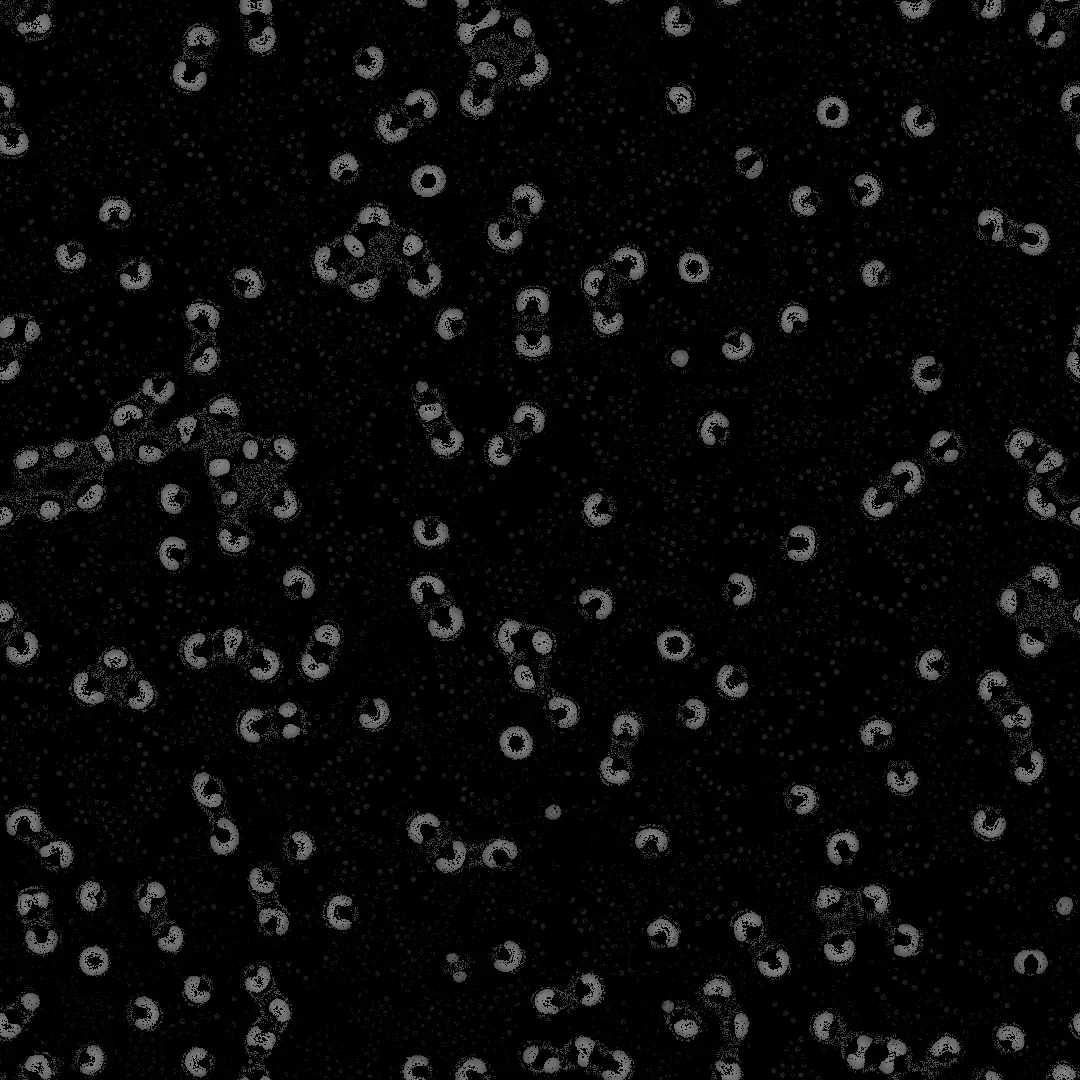
Genuary 2026 — Day 9

Experiments
Genuary 2026
01
Details
01.1
/
TYPE
Generative Art
01.2
/
TOOLS
TouchDesigner/GLSL/Python
01.3
/
DATE
January 2026
01.4
/
WEBSITE
https://genuary.art/
Genuary 2026
Genuary is an annual community event in which
generative artists and creative coders worldwide create one piece of code art
per day throughout January, each responding to a daily prompt. Any language,
framework or medium is welcome — the prompts are starting points, not rules.
Work is shared publicly using hashtags such as #genuary and #genuary2026.
Prompts
| Day | Prompt |
|---|---|
| Jan 1 | One color, one shape |
| Jan 2 | Twelve principles of animation |
| Jan 3 | Fibonacci forever |
| Jan 4 | Lowres |
| Jan 5 | Write "Genuary" — avoid using a font |
| Jan 6 | Lights on/off |
| Jan 7 | Boolean algebra |
| Jan 8 | A city — create a generative metropolis |
| Jan 9 | Crazy automaton — cellular automata with crazy rules |
| Jan 10 | Polar coordinates |
| Jan 11 | Quine |
| Jan 12 | Boxes only |
| Jan 13 | Self portrait |
| Jan 14 | Everything fits perfectly |
| Jan 15 | Create an invisible object where only the shadows can be seen |
| Jan 16 | Order and disorder |
| Jan 17 | Wallpaper group |
| Jan 18 | Unexpected path |
| Jan 19 | 16×16 |
| Jan 20 | One line |
| Jan 21 | Bauhaus poster |
| Jan 22 | Pen plotter ready |
| Jan 23 | Transparency |
| Jan 24 | Perfectionist's nightmare |
| Jan 25 | Organic geometry |
| Jan 26 | Recursive grids |
| Jan 27 | Lifeform |
| Jan 28 | No libraries, no canvas, only HTML elements |
| Jan 29 | Genetic evolution and mutation |
| Jan 30 | It's not a bug, it's a feature |
| Jan 31 | GLSL day — create an artwork using only shaders |
Animations
Videos of all these sketches are available on my Instagram. Follow along for the latest works in progress and experiments.